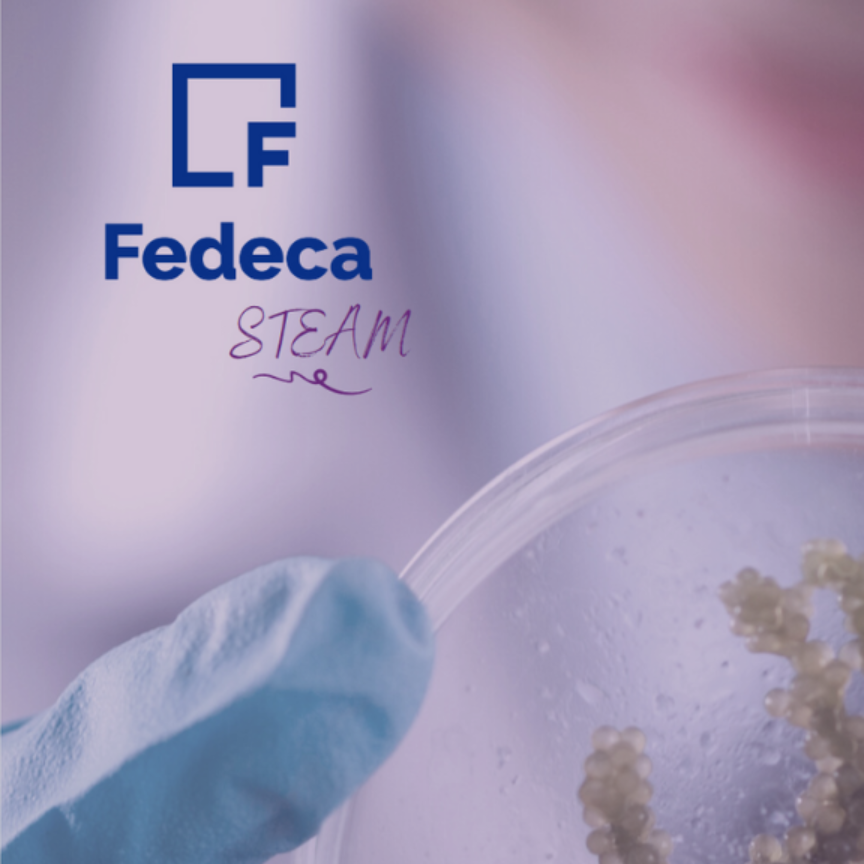
Fedeca

- Inicio
- Iniciativas
Iniciativas educativas de la Alianza STEAM
En esta sección puedes conocer diferentes iniciativas que ya están en marcha para promover el talento STEAM de niñas y mujeres. Son proyectos que impulsan las empresas y entidades miembros de la Alianza. Esta información la actualizamos periódicamente. Esperamos que te inspiren.
Entidad: Fundación ASTISalto de línea Dónde: Castilla y LeónSalto de línea Impulsa: Consejería de Familia e Igualdad de Oportunidades, Consejería de Educación y Consejería de Movilidad y Transformación Digital de la Junta de Castilla y León.Salto de línea Enfoque: tecnología y competencias softSalto de línea Etapa educativa: primaria
STEAM Talent Kids es un proyecto que ofrece recursos y actividades para la estimulación y desarrollo del talento y el fomento de las STEAM en el campo de la robótica y la programación así como en las competencias “soft” clave en el siglo XXI: creatividad, inteligencia emocional y comunicación
Entidad: Inspira STEAMSalto de línea Dónde: toda EspañaSalto de línea Impulsa: Universidad de DeustoSalto de línea Enfoque: mentoría grupalSalto de línea Etapa educativa: 6º primaria (11-12 años)
Inspira STEAM es un proyecto pionero basado en acciones de sensibilización y orientación que imparten mujeres voluntarias, profesionales de ciencia y tecnología. El proyecto busca establecer un vínculo entre la mentora y las chicas y chicos durante seis sesiones en horario lectivo. La iniciativa quiere que las chicas tengan un espejo en el que mirarse.
Entidad: CTICSalto de línea Dónde: AsturiasSalto de línea Impulsa: Gobierno del Principado de Asturias, Valnalon, FADESalto de línea Enfoque: orientación profesional, mentoringSalto de línea Etapa educativa: 3º y 4º de SecundariaSalto de línea Salto de línea MASSTEAM es una iniciativa de orientación inmersiva para la promoción de los estudios científico-tecnológicos en las chicas y jóvenes de 3º y 4º de Secundaria. Entre otras acciones, prevé encuentros con profesionales STEAM, como científicas y tecnólogas que desarrollen su actividad en Asturias.
Entidad: DigitalES, Real Academia de Ingeniería (RAI)Salto de línea Dónde: toda EspañaSalto de línea Impulsa: DigitalES, Real Academia de IngenieríaSalto de línea Enfoque: fomento de las vocaciones STEMSalto de línea Etapa educativa: a partir de 12 añosSalto de línea Salto de línea Generación A es la primera acción conjunta entre DigitalES y la Real Academia de Ingeniería. El compromiso de DigitalES es ayudar a las chicas a ser las ingenieras, informáticas y matemáticas del mañana. A través de esta iniciativa, 44 mujeres buscan orientar o servir de referentes para aquellas jóvenes que reúnen las habilidades para ser profesionales STEM en el futuro.
Entidades: Universidad de La Laguna y Fundación CEPSASalto de línea Dónde: Tenerife, CanariasSalto de línea Impulsa: Universidad de La Laguna, Fundación CEPSA Gobierno de Canarias, Fondo Social Europeo, Ministerio de Trabajo, Migraciones y Seguridad SocialSalto de línea Enfoque: orientación universitariaSalto de línea Etapa educativa: Bachillerato
Chicas con cienci@ull es un proyecto que busca fomentar las vocaciones científicas y tecnológicas entre las jóvenes de la isla de Tenerife. Se compone de un programa de actividades divulgativas, orientativas y motivadoras y herramientas que el profesorado puede utilizar en el aula.
Entidad: ByLineduSalto de línea Dónde: ValenciaSalto de línea Impulsa: Raspberry Pi FoundationSalto de línea Enfoque: programación informáticaSalto de línea Etapa educativa: de los 7 a los 17 añosSalto de línea Salto de línea CoderDojo Girls es el club de programación y robótica de la Asociación ByL Iniciatives Educatives para fomentar la cultura Maker y las vocaciones STEAM. Mediante este proyecto se proporciona a las chicas un entorno que les permite desarrollar sus habilidades y en el que todas tienen la oportunidad de aprender y ser creativas en un ambiente divertido, seguro y social.
Entidad: EseroSalto de línea Dónde: toda EspañaSalto de línea Impulsa: EseroSalto de línea Enfoque: fomento de las vocaciones STEMSalto de línea Etapa educativa: todas las edadesSalto de línea Salto de línea #EllasInspiranSteam nace con el objetivo de visibilizar a mujeres que trabajan dentro del ámbito aeroespacial y tecnológico para mostrar las carreras espaciales como una opción al alcance de todas. Estas mujeres, que con su trabajo están contribuyen al desarrollo científico-técnico, sirven de ejemplo a la hora de fomentar las vocaciones científicas entre el alumnado femenino.
Entidad: FECYT, EverisSalto de línea Dónde: toda EspañaSalto de línea Impulsa: Ministerio de Ciencia e Innovación, BBVASalto de línea Enfoque: competencias digitales, creación de videojuegosSalto de línea Etapa educativa: Educación Primaria (de 7 a 12 años)Salto de línea Salto de línea #Girlsgonna, un proyecto educativo de la Fundación Española para la Ciencia y la Tecnología (FECYT) y la consultora multinacional Everis, del Grupo NTT DATA. Consiste en unos talleres online sobre conocimientos de programación destinados a niños y niñas de Educación Primaria, en los que se da visibilidad a perfiles de mujeres científicas y tecnólogas.
Entidad: EdelvivesSalto de línea Dónde: toda EspañaSalto de línea Impulsa: EdelvivesSalto de línea Enfoque: entorno dinámico de aprendizajeSalto de línea Etapa educativa: Infantil, Primaria y Secundaria (de 3 a 15 años)Salto de línea Salto de línea GO STEAM es una plataforma que reúne material para trabajar las STEAM en clase, con propuestas en constante actualización, itinerarios y recursos combinables. Incluye actividades y herramientas relacionadas con impresión 3D, mecánica, música, robótica, ciencia, tecnología, diversidad funcional y mucho más.
Entidad: AMITSalto de línea Dónde: toda EspañaSalto de línea Impulsa: Gettingbetter, Dospassos, Parlamento EuropeoSalto de línea Enfoque: recuperar referentes científicosSalto de línea Etapa educativa: de Primaria en adelanteSalto de línea Salto de línea #NoMoreMatildas es la iniciativa de la Asociación de Mujeres Investigadoras y Tecnólogas (AMIT), cuya razón de ser es visibilizar y fomentar el papel de la mujer en la ciencia, para alertar sobre una preocupante cifra: en la actualidad, las mujeres representan el 28% del alumnado en carreras científicas en el mundo, según la Unesco. En las carreras STEM, la desigualdad se está agravando.
Entidad: InspiringirlsSalto de línea Dónde: Oviedo, Valencia, Cádiz, MadridSalto de línea Impulsa: Inspiringirls, CacharelSalto de línea Enfoque: reforzar aptitudes de liderazgo y uso responsable de la tecnologíaSalto de línea Etapa educativa: Secundaria, Bachillerato (de 14 a 17 años)Salto de línea Salto de línea Club IG Cacharel es un programa de formación interdisciplinar dirigido a chicas adolescentes con el objetivo de reforzar sus aptitudes de liderazgo para el logro de sus metas y objetivos de futuro, así como aprender el uso responsable de la tecnología.
Entidad: Colegio Oficial de Ingenieros de TelecomunicaciónSalto de línea Dónde: toda EspañaSalto de línea Impulsa: Cellnex, Fundación Orange, Hispasat, Telefónica, Vantage Towers, Banco Sabadell Professional, Isdefe, TeldaSalto de línea Enfoque: reconocimiento a la trayectoria profesionalSalto de línea Etapa educativa: -Salto de línea Salto de línea El Premio Pioneras_IT es un reconocimiento que el Colegio Oficial de Ingenieros de Telecomunicación (COIT) otorga anualmente a una Ingeniera de Telecomunicación, para poner en valor su trayectoria y recorrido profesional como “pionera”.
Entidad: Inspiring GirlsSalto de línea Dónde: toda EspañaSalto de línea Impulsa: Inspiring Girls, HuaweiSalto de línea Enfoque: desarrollo de habilidades digitales y tecnológicasSalto de línea Etapa educativa: Primaria, Secundaria (de 10 a 13 años)Salto de línea Salto de línea El Club Tech IG es un lugar de encuentro para niñas curiosas y apasionadas.Las participantes se familiarizarán con habilidades tan importantes como inteligencia emocional para la eficaz gestión del proyecto, diseño digital, programación de web y app, marketing digital, etc. Aprenderán sobre nuevas tendencias en tecnología y lo harán divirtiéndose y haciendo amigas de su edad.
Entidad: Instituto de las MujeresSalto de línea Dónde: toda EspañaSalto de línea Impulsa: Ministerio de IgualdadSalto de línea Enfoque: sensibilizar a mujeres y hombres en el valor social de la igualdad como eje para el desarrollo socialSalto de línea Etapa educativa: -Salto de línea Salto de línea La Escuela Virtual de Igualdad (EVI) es un espacio de formación digital dirigido a fomentar la igualdad de oportunidades entre mujeres y hombres a través de acciones formativas gratuitas enmarcadas en diferentes ámbitos. Los objetivos son sensibilizar en el valor social de la igualdad como eje para el desarrollo social.
Entidad: SamsungSalto de línea Dónde: toda EspañaSalto de línea Impulsa: SamsungSalto de línea Enfoque: programa formativo para mujeres en el ámbito de la programación webSalto de línea Etapa educativa: a partir de los 18 añosSalto de línea Salto de línea DesArrolladoras es un programa formativo que tiene como objetivo el impulso del talento femenino en las profesiones STEM y la capacitación de las mujeres españolas en el sector de la programación y el diseño web, debido a la escasez de mujeres en España en el campo de la ingeniería y la tecnología.
Entidad: Federación Mujeres JóvenesSalto de línea Dónde: Comunidad de MadridSalto de línea Impulsa: Consejería de Políticas Sociales y Familia de la Comunidad de MadridSalto de línea Enfoque: herramientas digitales para la inserción sociolaboralSalto de línea Etapa educativa: de los 18 a los 35 añosSalto de línea Salto de línea Jóvenes y tecnológicas en el mundo laboral es un Programa de Federación Mujeres Jóvenes con el objetivo de dotar a las mujeres jóvenes de la Comunidad de Madrid de las herramientas digitales necesarias para su inserción sociolaboral.
Entidad: Federación Mujeres JóvenesSalto de línea Dónde: toda EspañaSalto de línea Impulsa: Ministerio de Sanidad, Consumo y Bienestar SocialSalto de línea Enfoque: eliminación de la brecha digitalSalto de línea Etapa educativa: de los 18 a los 35 añosSalto de línea Salto de línea Mujeres Tecnológicas es un programa de Federación Mujeres Jóvenes, que nace como un Programa para la Inserción Sociolaboral de las Mujeres Jóvenes, teniendo como objetivo principal la eliminación de la brecha digital. Está financiado por el Ministerio de Sanidad, Consumo y Bienestar Social.
Entidad: Fundación Mujeres, Fundación Cibervoluntarios y Google.orgSalto de línea Dónde: toda EspañaSalto de línea Impulsa: Fundación Mujeres, Fundación Cibervoluntarios y Google.orgSalto de línea Enfoque: formación en competencias digitalesSalto de línea Etapa educativa: a partir de los 18 añosSalto de línea Salto de línea Digitalizadas busca potenciar la participación, empleabilidad, y emprendimiento de las mujeres, especialmente de entorno rural, a través de la adquisición de competencias digitales y el uso de herramientas tecnológicas.
Entidad: Ingeniera SoySalto de línea Dónde: Por confirmarSalto de línea Impulsa: CaixaForumSalto de línea Enfoque: premiar iniciativas, personas o entidades que impulsan la presencia de niñas y mujeres en STEMSalto de línea Etapa educativa: -Salto de línea Salto de línea Los I Premios ISOY quieren premiar aquellas iniciativas, personas, instituciones o empresas que buscan impulsar la presencia y participación de niñas y mujeres en áreas educativas y ámbitos STEM. La entrega de los I PREMIOS ISOY, que contará con un total de 8 categorías premiadas, tendrá lugar en Marzo-Abril 2022.
Entidad: Power to Code, Talento STEMSalto de línea Dónde: toda EspañaSalto de línea Impulsa: Technovation, BBVASalto de línea Enfoque: resolver problemas a través de la tecnologíaSalto de línea Etapa educativa: Primaria, Secundaria, Bachillerato (de 10 a 18 años)Salto de línea Salto de línea Technovation es el concurso internacional para acercar la tecnología y el emprendimiento a las niñas más grande del mundo. En España han participado ya más de 1.500 niñas. Pueden inscribirse niñas de 10 a 18 años en equipos de hasta cinco personas con el apoyo de madres, padres, profesores de colegios e institutos.
Entidad: Ikaslan BizkaiaSalto de línea Dónde: BizkaiaSalto de línea Impulsa: Departamento de Empleo, Inclusión Social e Igualdad de la Diputación Foral de BizkaiaSalto de línea Enfoque: descubrir las aplicaciones y oportunidades que ofrece el área científico-tecnológicaSalto de línea Etapa educativa: SecundariaSalto de línea Salto de línea Generando vocaciones. STEAM LH es un proyecto de Ikaslan Bizkaia que tiene como objetivo fomentar inspirar vocaciones y aspiraciones profesionales, con especial atención a las alumnas. Para ello trabaja en tres ámbitos: educativo, familiar/escolar y de la empresa.
Entidad: CSICSalto de línea Dónde: toda EspañaSalto de línea Impulsa: Ministerio de Ciencia e InnovaciónSalto de línea Enfoque: actualizar los conocimientos en ciencia y tecnología del profesoradoSalto de línea Etapa educativa: -
CSIC en la escuela es un proyecto del Consejo Superior de Investigaciones Científicas (CSIC) en el que investigadores y maestros trabajan conjuntamente para introducir y fomentar la enseñanza de la ciencia desde las primeras etapas de la educación en igualdad de género. Dispone también de una web con recursos para profesores.
Entidad: Fundación ASTISalto de línea Dónde: toda EspañaSalto de línea Impulsa: Consejería de Familia e Igualdad de Oportunidades de la Junta de Castilla y León, a través de la Dirección General de la Mujer, y Consejería de Educación de la Junta de Castilla y León. Salto de línea Enfoque: descubrir las áreas STEAM de la mano de mujeres profesionalesSalto de línea Etapa educativa: Secundaria, Bachillerato, UniversidadSalto de línea Salto de línea STEM Talent Girl es un proyecto destinado a fomentar el interés de las niñas en materias STEAM. Está desplegado en tres programas: Science for Her, para alumnas de ESO; Mentor Women, para chicas de Bachillerato y universitarias; y Real Work para universitarias que se estén formando en disciplinas STEM.
Entidad: Universidad Isabel ISalto de línea Dónde: toda EspañaSalto de línea Impulsa: Universidad Isabel ISalto de línea Enfoque: poner en relieve el papel de mujeres representativas en diferentes campos de conocimientoSalto de línea Etapa educativa: -Salto de línea Salto de línea Hoy hablamos de... es una iniciativa que trata de dar a conocer y de poner en relieve el papel y la importancia de mujeres representativas en diferentes campos del conocimiento, tales como la ciencia, la historia, la abogacía o la educación. Lo hace recordando su labor en el desarrollo histórico, social y cultural.
Entidad: AEPDSalto de línea Dónde: toda EspañaSalto de línea Impulsa: Ministerio de JusticiaSalto de línea Enfoque: debatir sobre la igualdad de género en el ámbito de la protección de datosSalto de línea Etapa educativa: -Salto de línea Salto de línea Innovación y Protección de Datos. Mujer y Ciencia son una serie de seminarios web organizados por la Agencia Española de Protección de Datos (AEPD), con los que pretende mantener un debate riguroso sobre temas de actualidad, en este caso en el ámbito de la tecnología y la protección de datos y de la igualdad de género.
Entidad: FADESalto de línea Dónde: AsturiasSalto de línea Impulsa: Gobierno de Asturias, iasturas innovaciónSalto de línea Enfoque: orientación y promoción del talento femenino hacia los estudios STEAMSalto de línea Etapa educativa: alumnado preuniversitarioSalto de línea Salto de línea FADE_MASSTEAM, iniciativa impulsada por FADE, y en la que colabora CTIC, pretende fomentar las vocaciones científico-tecnológicas en el alumnado preuniversitario en general, y en alumnas en particular, sobre las oportunidades de desarrollo profesional y personal en torno a las competencias STEAM.
Entidad: Fablab LeónSalto de línea Dónde: Castilla y leónSalto de línea Impulsa: Fablab LeónSalto de línea Enfoque: fortalecer las habilidades STEAM de la niñasSalto de línea Etapa educativa: Primaria (entre 8 y 12 años)Salto de línea Salto de línea Poderosas es un proyecto de Fablab León con el fin de aumentar el interés por la tecnología, la ciencia y la ingeniería a través de experiencias educativas innovadoras. El proyecto troncal es un programa educativo diseñado en el marco STEAM, para alentar el compromiso con la tecnología, promover la autoconfianza y apoyar la aspiración de carreras técnicas.
Entidad: Fundación Secretariado GitanoSalto de línea Dónde: Cáceres, Granada, Santiago de Compostela, Albacete, Jaén, Madrid-Carabanchel y Campo de GibraltarSalto de línea Impulsa: Fundación TelefónicaSalto de línea Enfoque: adquirir nociones clave sobre las estructuras de pensamiento tras las lógicas de la programaciónSalto de línea Etapa educativa: Primaria, ESO, BachilleratoSalto de línea Salto de línea Promociona Digital es un proyecto que aborda, con perspectiva de género, el reto de mejorar la capacitación digital del alumnado gitano y sus familias, para garantizar el éxito escolar de los estudiantes y lograr la plena incorporación de las familias a una ciudadanía digital.
Entidad: Fundación Secretariado Gitano, Cruz Roja, Fundación AccentureSalto de línea Dónde: toda EspañaSalto de línea Impulsa: Fondo Social Europeo a través del Ministerio de Empleo y Seguridad Social, Fundación AccentureSalto de línea Enfoque: competencias digitales para mejorar la inserción laboral de las personas en riesgo de exclusión socialSalto de línea Etapa educativa: de los 18 años en adelanteSalto de línea Salto de línea #EmpleandoDigital es un proyecto que nace con el objetivo de dar respuesta a las necesidades, en materia de empleabilidad de los colectivos más vulnerables, ante un mercado laboral modificado por la transformación digital.
Entidad: Fundación Secretariado Gitano, Fundación OrangeSalto de línea Dónde: Madrid, Córdoba, León, Málaga, Valencia, Barcelona, Badajoz, Gijón y LugoSalto de línea Impulsa: Fondo Social Europeo a través del Ministerio de Empleo y Seguridad SocialSalto de línea Enfoque: competencias digitales para empoderar a las mujeres gitanasSalto de línea Etapa educativa: de 16 años en adelanteSalto de línea Salto de línea EDYTA promueve la educación digital de mujeres en situación de vulnerabilidad o en riesgo de exclusión social y con baja empleabilidad, así como la transformación digital de las entidades a las que pertenecen.
Entidad: IberdrolaSalto de línea Dónde: toda EspañaSalto de línea Impulsa: IberdrolaSalto de línea Enfoque: desarrollo profesional de los jóvenes en el sector eléctricoSalto de línea Etapa educativa: desde los 15 años en adelanteSalto de línea
Profesionales del Futuro en el Sector Eléctrico es un programa del Plan Jóvenes, impulsado y liderado por Iberdrola, dirigido a estudiantes de Formación Profesional de toda España. Consiste en unas jornadas informativas sobre las formaciones y posibles salidas laborales del sector eléctrico.
Entidad: Universidad Carlos III de MadridSalto de línea Dónde: Leganés, MadridSalto de línea Impulsa: Universidad Carlos III de MadridSalto de línea Enfoque: acercar de forma amena las investigaciones en telecomunicaciones, informática, bioingeniería, electricidad y energías renovablesSalto de línea Etapa educativa: ESO, Bachillerato y ciclos formativosSalto de línea Salto de línea STEM 4 Girls consiste en una serie de talleres prácticos que buscan acercar el trabajo riguroso y de investigación que se realiza en los campos de telecomunicaciones, informática, bioingeniería, electricidad y energías renovables.
Entidad: Talent WomanSalto de línea Dónde: MálagaSalto de línea Impulsa: Talent WomanSalto de línea Enfoque: compartir experiencias de mujeres referentes en STEAMSalto de línea Etapa educativa: -Salto de línea Salto de línea Talent Woman España es un foro para fomentar las vocaciones STEAM entre niñas y adolescentes que tendrá lugar el 2 y 3 de noviembre de 2022 en el Palacio de Ferias y Congresos de Málaga. En esta 5ª edición, mujeres referentes en las profesiones STEAM podrán compartir su experiencia y ser modelos para jóvenes.
Entidad: CSICSalto de línea Dónde: toda EspañaSalto de línea Impulsa: Ministerio de Ciencia e InnovaciónSalto de línea Enfoque: despertar vocaciones científicasSalto de línea Etapa educativa: Primaria (de 6 a 12 años)Salto de línea Salto de línea CSIC4girls tiene como objetivo despertar vocaciones científicas en niñas de Primaria, dándoles la oportunidad de entrar en contacto con la cultura científica y de explorar y experimentar con la ciencia y la tecnología. Ofrece talleres online e interactivos, impartidos por científic@s del CSIC y para los que se ha contado con asesores en creatividad y Design Thinking.
Entidad: Plan InternationalSalto de línea Dónde: toda EspañaSalto de línea Impulsa: Plan InternationalSalto de línea Enfoque: promover la alfabetización digitalSalto de línea Etapa educativa: todasSalto de línea Salto de línea Girls for Real es una iniciativa para promover la alfabetización digital de niñas, adolescentes y jóvenes a través de la educación. Además de las habilidades técnicas, apuesta por incluir en esta educación la resolución de problemas y las herramientas de protección frente a la desinformación; alfabetización en información y datos; creación de contenidos; y habilidades de liderazgo.
Entidad: Plan InternationalSalto de línea Dónde: Unión EuropeaSalto de línea Impulsa: Plan InternationalSalto de línea Enfoque: aumentar el número de chicas y mujeres en ITSalto de línea Etapa educativa: de 18 a 29 años que no estén ni estudiando ni trabajando
Women4IT es un programa internacional que impulsa la formación en competencias digitales y promueve oportunidades laborales para mujeres jóvenes en la economía digital. El objetivo es que se formen en perfiles digitales 700 chicas y mujeres jóvenes y que 500 consigan oportunidades laborales.
Entidad: Fundación AquaeSalto de línea Dónde: casi toda EspañaSalto de línea Impulsa: Fundación AquaeSalto de línea Enfoque: fomentar el interés de las niñas por las STEMSalto de línea Etapa educativa: PrimariaSalto de línea
Aquae STEM es un programa destinado a fomentar e impulsar el interés de las niñas por las disciplinas STEM a través de actividades prácticas, retos y debates en el aula. Esta iniciativa, alineada con los Objetivos de Desarrollo Sostenible de la Agenda 2030, está impactando en más de 50 colegios de la geografía española y en más de 2.500 alumnas de 2º a 6º de primaria.Salto de línea
Entidad: CSICSalto de línea Dónde: toda EspañaSalto de línea Impulsa: Ministerio de Ciencia e InnovaciónSalto de línea Enfoque: promover la cienciaSalto de línea Etapa educativa: todas
El CSIC promueve actividades STEAM en distintas Comunidades Autónomas, desde la divulgación científica en barrios vulnerables hasta conferencias, programas escolares y certámenes educativos, para acercar los mundos de la ciencia y de la escuela, poniendo en contacto a los científicos y a los maestros en ejercicio. En este PDF encontraréis un listado de todas estas actividades.
Entidad: FedecaSalto de línea Dónde: toda EspañaSalto de línea Impulsa: FedecaSalto de línea Enfoque: encuentros de mujeres líderesSalto de línea Etapa educativa: -Salto de línea Salto de línea La II Edición WOMEN LEADERSHIP, que tendrá lugar el mes de marzo, y la III y IV Edición WOMEN MENTORSHIP, que se celebrán en mayo y en octubre, son encuentros de mujeres líderes y constituyen las principales iniciativas llevadas a cabo por la Comisión de Igualdad de Fedeca durante este año 2022 para eliminar los estereotipos y roles de género.
Entidad: CaixaBank, MicrosoftSalto de línea Dónde: toda EspañaSalto de línea Impulsa: CaixaBank, MicrosoftSalto de línea Enfoque: premiar la excelencia académica de las estudiantes de grados STEAMSalto de línea Etapa educativa: de 18 años en adelanteSalto de línea Salto de línea Los Premios WONNOW otorgan un premio en metálico a la estudiante con mejor expediente académico, trayectoria personal, profesional y social de un grado STEM. 10 estudiantes tendrán acceso a una beca remunerada para trabajar en CaixaBank y todas participarán en un programa de mentoring con Microsoft.
Entidad: CaixaBank y la Universidad de LleidaSalto de línea Dónde: toda EspañaSalto de línea Impulsa: CaixaBank y la Universidad de LleidaSalto de línea Enfoque: premiar la excelencia académica de las estudiantes del sector agroalimentarioSalto de línea Etapa educativa: de 18 años en adelante
La Cátedra AgroBank “Calidad e Innovación en el sector Agroalimentario” reconoce la excelencia académica a través de premios a trabajos académicos que pueden suponer un avance para el sector agroalimentario, como el Premio al mejor Trabajo Final de Máster (TFM) relacionado con la Calidad o la Innovación en dicho sector.
Entidad: CaixaBankSalto de línea Dónde: toda EspañaSalto de línea Impulsa: CaixaBankSalto de línea Enfoque: plataforma de contenidos y búsqueda de empleoSalto de línea Etapa educativa: -Salto de línea Salto de línea People Xperience Hub es la comunidad de talento del Grupo CaixaBank en la que participan empresas del grupo, creando un ecosistema que potencia la transformación y la colaboración sobre las últimas tendencias del mercado. Innovación, personas, tecnología, economía, sostenibilidad y más. La comunidad está abierta a todo aquel que quiera acercarse sea o no candidato/a, cliente/a o empleado/a.
Entidad: Barcelona ActivaSalto de línea Dónde: Barcelona y onlineSalto de línea Impulsa: Ayuntamiento de BarcelonaSalto de línea Enfoque: talleres digitalesSalto de línea Etapa educativa: Primaria (de 6 a 12 años)Salto de línea Salto de línea #estàsON es una serie de talleres experienciales presenciales o virtuales dirigidos tanto a niñas como a niños, orientados a despertar el interés y la curiosidad en el ámbito científico y tecnológico mediante el aprendizaje lúdico, dando a conocer las principales disciplinas STEAM como la ciencia, robótica, física, química o tecnología.
Entidad: Ingeniera SoySalto de línea Dónde: toda EspañaSalto de línea Impulsa: First, Lego EducationSalto de línea Enfoque: robótica y programaciónSalto de línea Etapa educativa: Primaria, Secundaria (de 6 a 16 años)Salto de línea Salto de línea FIRST LEGO League es un programa educativo por equipos que fomenta las vocaciones STEM entre los jóvenes de 6 a 16 años a través de la robótica educativa, la programación y la investigación. Orientado a niños y niñas de Educación Primaria y Secundaria, con su profesor/a aprenderán a aplicar conocimientos adquiridos de física y mecánica y mejorarán sus nociones de programación.
Entidad: Telefónica Open Innovation CampusSalto de línea Dónde: toda EspañaSalto de línea Impulsa: TelefónicaSalto de línea Enfoque: organización de jornadas y actividadesSalto de línea Etapa educativa: educación secundaria y estudios universitariosSalto de línea Salto de línea El programa #GirlsLoveTech impulsa y conecta sinergias con otras entidades, para el desarrollo de talleres, masterclass e iniciativas STEAM, todas ellas dirigidas a niñas y jóvenes, mostrando referentes reales que inspiren con el fin de transmitir la pasión por la innovación, la tecnología o el emprendimiento.
Entidad: Barcelona Activa, Barcelona Supercomputing CenterSalto de línea Dónde: BarcelonaSalto de línea Impulsa: Ayuntamiento de Barcelona, Ministerio de Ciencia e InnovaciónSalto de línea Enfoque: enseñar los principios de la supercomputaciónSalto de línea Etapa educativa: PrimariaSalto de línea Salto de línea Las Visitas en femenino al Barcelona Supercomputing Center, gratuitas, consisten en ocho juegos para que los más pequeños aprendan qué es un superordenador, para qué sirve, quién lo utiliza y conceptos básicos de supercomputación y pensamiento computacional.
Entidad: Barcelona Activa, Universitat Politècnica de CatalunyaSalto de línea Dónde: CataluñaSalto de línea Impulsa: Consejería de Educación de la GeneralitatSalto de línea Enfoque: atraer talento femenino y orientar al profesoradoSalto de línea Etapa educativa: Primaria, Secundaria (de 9 a 14 años)Salto de línea Salto de línea Aquí STEAM es una iniciativa para atraer talento femenino a los estudios de tecnología e ingeniería. Incluye un programa de formación para el profesorado de centros de Primaria y ESO, orientado a introducir la perspectiva de género en la educación.
Entidad: Ministerio para la Transición Ecológica y el Reto DemográficoSalto de línea Dónde: Madrid y onlineSalto de línea Impulsa: Ministerio para la Transición Ecológica y el Reto DemográficoSalto de línea Enfoque: visibilizar mujeres que trabajan en la moda sostenibleSalto de línea Etapa educativa: Formación profesional y estudios universitariosSalto de línea Salto de línea Ellas cambian el mundo es una serie de encuentros organizados en marzo que visibilizarán a mujeres que contribuyen a la moda con conciencia de sostenibilidad.
Entidad: Generación CODESalto de línea Dónde: Madrid, Sevilla, BarcelonaSalto de línea Impulsa: CODE, BBVASalto de línea Enfoque: bases de la programaciónSalto de línea Etapa educativa: de 7 a 14 años (Primaria, Secundaria)
CODE ofrece bootcamps presenciales dirigidos a niños de entre 7 y 14 años para promover el aprendizaje de la programación en edades tempranas. La programación fomenta las vocaciones STEM y el emprendimiento. Todos los sábados de 9:30 a 13: 30 en las instalaciones de The Bridge en Madrid o en las instalaciones de la empresa que patrocina la formación.
Entidad: Acciona, CODE.orgSalto de línea Dónde: internacionalSalto de línea Impulsa: Acciona, CODE.orgSalto de línea Enfoque: formación STEAM para cambiar el mundoSalto de línea Etapa educativa: de 18 años en adelante
Homeward Bound es una red internacional de 10.000 mujeres con formación STEMM para liderar el cambio hacia un mundo más sostenible y justo. Un viaje de un año de formación en liderazgo, estrategia y visibilidad, que termina con tres semanas en la Antártida. Más de 600 mujeres de todo el mundo, 15 españolas, han formado parte de este programa
Entidad: FPEmpresaSalto de línea Dónde: todo EspañaSalto de línea Impulsa: EsprinetSalto de línea Enfoque: cumplir con los objetivos ODSSalto de línea Etapa educativa: Formación ProfesionalSalto de línea Salto de línea FPEmpresa quiere visibilizar el talento femenino en aquellas familias profesionales de FP donde la presencia de mujeres es testimonial. Para obtener el premio habrá que idear una solución tecnológica que contribuya a alcanzar al menos uno de los objetivos de desarrollo sostenible y fomentar la igualdad de género.
Entidad: EdelvivesSalto de línea Dónde: toda EspañaSalto de línea Impulsa: Edelvives, Samsung, Intel, Advanced Education, Dell, Academia de Inventores, EINASalto de línea Enfoque: convertir escuelas en centros de referencia STEAMSalto de línea Etapa educativa: todas las edadesSalto de línea Salto de línea Edelvives ofrece a los centros educativos la oportunidad de ser centros de referencia STEAM, una referencia avalada por los impulsores de la iniciativa pensada para escuelas que deseen especializarse en estas disciplinas.
Entidad: HETELSalto de línea Dónde: País VascoSalto de línea Impulsa: HETEL, BBK, EuskaltelSalto de línea Enfoque: aportar referentesSalto de línea Etapa educativa: ESO y Bachillerato
La iniciativa de HETEL tiene como objetivo animar a las mujeres a romper moldes y realizar estudios de Formación Profesional industrial. Con esta campaña se pretende dar a conocer profesiones técnicas a las mujeres mediante una serie de vídeos sobre mujeres especializadas en dichos estudios.
Entidad: Fundación MujeresSalto de línea Dónde: toda EspañaSalto de línea Impulsa: Ministerio de Derechos Sociales y Agenda 2030, Ministerio de Igualdad, Junta de ExtremaduraSalto de línea Enfoque: recursos para fomentar la coeducaciónSalto de línea Etapa educativa: todasSalto de línea Salto de línea Educar en Igualdad ofrece recursos educativos, actividades e iniciativas entre las que destaca el fomento de las carreras STEAM en niñas y adolescentes y las formaciones, los encuentros, el asesoramiento y la resolución de dudas a los agentes educativos.
Entidad: BQ EducaciónSalto de línea Dónde: EspañaSalto de línea Impulsa: BQ Educación y Macmillan EducationSalto de línea Enfoque: fomentar las vocaciones STEAM entre las niñasSalto de línea Etapa educativa: Primaria y Secundaria
BMaker es un proyecto de BQ Education y Macmillan Education que busca que niños y niñas pasen de usuarios a creadores de tecnología, desarrollen sus competencias digitales y trabajen soft skills como la imaginación, la creatividad o el trabajo en equipo. Incluye una solución para el aula (bMaker School) y actividades extraescolares (bMaker Academy).
Entidad: Fundación ASTI, CaixaBank Dualiza y Fundación Empresa Familiar de Castilla y LeónSalto de línea Dónde: Castilla y LeónSalto de línea Impulsa:Consejería de Educación de la Junta de Castilla y LeónSalto de línea Enfoque: sensibilización, orientación profesional, mentoring y empleabilidadSalto de línea Etapa educativa: ESO, Bachillerato, Formación Profesional
FP STEAM es un proyecto para incrementar la presencia de las mujeres en los Grados STEAM e Industriales de FP con el fin de superar la brecha de género mediante diversas actividades y los FP STEAM Awards, que premian a alumnas, empresas y centros.
Entidad: CreáticaSalto de línea Dónde: MadridSalto de línea Impulsa: CreáticaSalto de línea Enfoque: fomento vocaciones STEAM y reducción brecha digital de géneroSalto de línea Etapa educativa: Desde 5º de primaria a 2º Bachillerato
Tech4Girls es un espacio de experimentación con las tecnologías dirigido especialmente a chicas de entre 10 y 15 años en el que probar su potencial mientras se crean y divierten para así disminuir la Segunda Brecha Digital. Ofrece a las chicas experiencias tempranas en el ámbito tecnológico sin ideas preconcebidas.
Entidad: IBMSalto de línea Dónde: EspañaSalto de línea Impulsa: responsabilidad Social Corporativa de IBMSalto de línea Enfoque: formación onlineSalto de línea Etapa educativa: Secundaria, Bachillerato y FPSalto de línea Salto de línea SkillsBuild es una plataforma online gratuita de formación en competencias digitales en áreas como la Ciberseguridad, la Inteligencia Artificial, Blockchain, Ciencia de Datos o la Computación en la nube, en habilidades transversales necesarias en la actualidad como la colaboración o la resolución creativa de problemas y metodologías de trabajo como Design Thinking o Agile.
Entidad: IBM y CreáticaSalto de línea Dónde: EspañaSalto de línea Impulsa: IBM y Creática ONGSalto de línea Enfoque: experencialSalto de línea Etapa educativa: PrimariaSalto de línea Salto de línea STEM en femenino tiene como objetivo inspirar a niñas en edades tempranas para que se ilusionen y apuesten por estudiar carreras en las áreas de Ciencia, Tecnología, Ingeniería y Matemáticas, y facilitar su formación en habilidades digitales. Familias y educadores encontrarán vídeos motivadores de mujeres STEM y otros recursos para utilizar en casa o en el aula
Entidad: IbermáticaSalto de línea Dónde: EspañaSalto de línea Impulsa: IbermáticaSalto de línea Enfoque: atraer y desarrollar el talento juniorSalto de línea Etapa educativa: Grado Medio y/o Superior, estudios universitariosSalto de línea Salto de línea La propuesta de la Junior University of Ibermática (JU) es atraer y desarrollar el talento junior, a través de la incorporación de becarios, que pasarán por un proceso de aprendizaje de conocimientos técnicos y habilidades, en el que, si demuestran la actitud, capacidad y desempeño adecuado, acabarán incorporándose a nuestros proyectos.
Entidad: Coding GiantsSalto de línea Dónde: onlineSalto de línea Impulsa: Coding Giants, GlovoSalto de línea Enfoque: programaciónSalto de línea Etapa educativa: de 12 a 18 años
Junto con Glovo y su proyecto Women in Tech, en Coding Giant estan preparando bootcamps de verano para jóvenes. 5 clases de lunes a viernes de 90 minutos, totalmente gratuitos. Preparamos cursos de desarrolladoras de páginas web, creadoras de videojuegos, bases de datos, Unity y más.
Entidad: Coding GiantsSalto de línea Dónde: online, Madrid, BarcelonaSalto de línea Impulsa: Coding GiantsSalto de línea Enfoque: programaciónSalto de línea Etapa educativa: de 6 a 18 años
El objetivo de Programa con Gigantes es promover el aprendizaje de la programación, el uso responsable de internet y las nuevas tecnologías y potenciar las vocaciones científicas y tecnológicas entre niñ@s y jóvenes. Siempre dan prioridad a las chicas y tratan de que los grupos estén equilibrados entre chicas y chicos.
Entidad: Fundación VodafoneSalto de línea Dónde: Aragón, Baleares, Castilla y León, Andalucía, Galicia y MadridSalto de línea Impulsa: Fundación Vodafone y Universidad de SalamancaSalto de línea Enfoque: Juego y experimentaciónSalto de línea Etapa educativa: Primaria
DigiCraft es un programa educativo que promueve el desarrollo de la competencia digital de docentes y alumnado de Educación Primaria a través de metodologías activas que combinan el juego y la experimentación y que persigue romper la brecha digital en las niñas, quienes se acercan a la tecnología de una forma más motivadora con el aprendizaje y desarrollo de las competencias digitales recogidas en DigComp (el marco de competencia digital europeo).
Entidad: Inspiring Girls - Technovation 23Salto de línea Dónde:Castilla y LeónSalto de línea Impulsa: Technovation, BBVASalto de línea Enfoque: programaciónSalto de línea Etapa educativa: de 6 a 18 años
Technovation Challenge es el mayor concurso mundial de tecnología dirigido a niñas de entre 8 y 18 años. El objetivo es empoderar a las chicas para que lideren el próximo cambio tecnológico. La finalidad es dar respuesta a los problemas sociales de su entorno desarrollando una aplicación móvil (APP) o un prototipo de Inteligencia Artificial (AI)
Entidad: Universidad Carlos III de MadridSalto de línea Dónde: Madrid (Campus de Getafe y Leganés)Salto de línea Impulsa: Universidad Carlos III de MadridSalto de línea Enfoque: Talleres, competiciones, actividades de mentoringSalto de línea Etapa educativa: ESO y Bachillerato
STEM for Girls que organiza la Universidad Carlos III de Madrid, se compone de talleres, competiciones, actividades de mentoring y también incluye a las artes escénicas. Está dirigido a niñas y jóvenes, su objetivo es fomentar el interés y la curiosidad por las materias stem y generar referentes.
Entidad: ASATA Patronal de la Economía Social de Asturias.Salto de línea Dónde: Asturias , Cantabria y Extremadura.Salto de línea Impulsa: Consejería de Ciencia, Innovación y Universidad del Principado de Asturias, Fundación Accenture, Fundación Ibercaja, entre otros.Salto de línea Enfoque: Itinerarios formativos disruptivos,Salto de línea Etapa educativa: Primaria
#DespertandoVocaciones pretende conectar, educar y mentorizar proyectos que despierten vocaciones STEAM desde edades tempranas para generar un cambio cultural en el tratamiento del currículo educativo.
Entidad: Johnson & JohnsonSalto de línea Dónde: InternacionalSalto de línea Impulsa: Johnson & JohnsonSalto de línea Enfoque: MotivacionalSalto de línea Etapa educativa: Primaria, Secundaria, Bachillerato, Formación Profesional, Universidad
STEM²D es un programa social cuyo reto es impactar en 2 millones de niñas para 2025. Para ello, se promueve el interés por las carreras científicas y tecnológicas entre las niñas y jóvenes a través de talleres, charlas motivacionales, experimentos, etc. en las que participan voluntarios de Johnson & Johnson
Entidad: Empieza por Educar (ExE)Salto de línea Dónde: MadridSalto de línea Impulsa: Fundación Iberdrola EspañaSalto de línea Enfoque: Docencia para colectivos vulnerablesSalto de línea Etapa educativa: Secundaria y FP
Con las Becas STEM Fundación Iberdrola -ExE se aspira despertar en las alumnas el interés por las STEM. El programa incluye un año de prácticas en un centro educativo en entorno socioeconómicamente vulnerable, donde estas docentes persiguen reducir el abandono escolar y motivar a las niñas hacia carreras STEM.
Entidad: Cátedra STEM MujerSalto de línea Dónde: MadridSalto de línea Impulsa: Universidad Pontificia Comillas, Fundación Iberdrola España y EMTSalto de línea Enfoque: Promover y fomentar las vocaciones STEM en estudiantesSalto de línea Etapa educativa: Primaria, ESO, Bachillerato y Formación Profesional
La Cátedra STEM Mujer realiza acciones para que niños, niñas y jóvenes conozcan el mundo STEM de manera útil, divertida y creativa, con el fin de promover vocaciones STEM. Con talleres prácticos, charlas de mujeres en profesiones STEM, visitas a centros tecnológicos, mentorías, difusión de pórsters de mujeres STEM, hackatones, etc. y asesoramiento a centros educativos que buscan dar a conocer a su alumnado los estudios STEM y sus salidas profesionales.
Entidad: Cátedra STEM MujerSalto de línea Dónde: MadridSalto de línea Impulsa: Universidad Pontificia Comillas, Fundación Iberdrola España y EMTSalto de línea Enfoque: Dar a conocer los estudios STEM entre orientadores y mejorar los conocimientos y habilidades de los profesores y futuros profesores en ciencia, tecnología, ingeniería y matemáticas.Salto de línea Etapa educativa: Orientadores y profesores de centros educativos y estudiantes de Grados de Educación.
Proyecto formativo de la Cátedra STEM Mujer para acercar a los orientadores y profesores al mundo STEM y las profesiones asociadas, con el objetivo de que puedan transmitirlo a sus alumnos y alumnas, con jornadas de orientación hacia Estudios STEM, materiales de difusión de salidas profesionales, talleres prácticos de formación, visitas a laboratorios, mesas redondas con profesionales STEM de hombres y mujeres, etc.
Entidad: Real Academia de Ingeniería (RAI)Salto de línea Dónde: Toda EspañaSalto de línea Impulsa: Real Academia de Ingeniería (RAI)Salto de línea Enfoque: Fomento de las vocaciones STEMSalto de línea Etapa educativa: Secundaria y Universidades
Mujer e Ingeniería es un proyecto de la Real Academia de Ingeniería para impulsar las vocaciones STEM entre las mujeres. Su objetivo prioritario es incentivar, promover, motivar e ilusionar a niñas y jóvenes para que conozcan las oportunidades que los estudios STEM pueden poner a su alcance.
A través de diferentes programas en centros escolares, universidades y empresas busca fomentar, acompañar e impulsar las carreras profesionales de mujeres en el ámbito de la Ingeniería.
Entidad: CASIOSalto de línea Dónde: Toda EspañaSalto de línea Impulsa: División Educativa CASIOSalto de línea Enfoque: 5 actividades competenciales para el aula y 17 científicas Salto de línea Etapa educativa: Primaria, Secundaria y Bachillerato
#científicasCASIO es una iniciativa artístico-educativa para visibilizar a científicas en las carcasas de las calculadoras escolares CASIO. Rompemos con estereotipos de género y damos referentes en el entorno STEAM. 17 artistas representan a 17 científicas.
Entidad: Campus 42 - Fundación TelefónicaSalto de línea Dónde: Madrid, Barcelona, Urduliz (Bizkaia), MálagaSalto de línea Impulsa: Fundación TelefónicaSalto de línea Enfoque: Programa formativo para mujeres en el ámbito de la programación web. Gratuito.Salto de línea Etapa educativa: a partir de los 18 años
Con el objetivo de impulsar el talento digital femenino, Fundación Telefónica ha creado las Piscine Discovery Women’s Edition, una experiencia sólo para mujeres, donde experimentar la metodología de 42, de forma presencial y 100% gratuita. Aprenderán HTML, CSS o JavaScript en los campus de España: 42Madrid, 42Barcelona, 42Urduliz (Bizkaia) y 42Málaga.
Entidad: HuaweiSalto de línea Dónde: EspañaSalto de línea Impulsa: HuaweiSalto de línea Enfoque: Incentivar mediante becas estudiantes españolas excelentes especializadas en ingeniería Salto de línea Etapa educativa: Bachillerato, Formación Profesional y Universidad, máster o doctorado.
“Seeds for the Future Scholarship (Futuro de las TIC Beca 2022 en España Huawei está dispuesta a trabajar con sus socios españoles para desarrollar el mejor talento digital y colaborar con las universidades españolas para transmitir las habilidades digitales, difundir esos conocimientos y reducir la brecha digital.
Entidad: RedeiaSalto de línea Dónde: toda EspañaSalto de línea Impulsa: RedeiaSalto de línea Enfoque: fomento de las vocaciones STEAMSalto de línea Etapa educativa: 3º y 4º de E.S.O
#RedeSTEAM es un concurso que busca fomentar las vocaciones científicas y tecnológicas entre las más jóvenes .Romper la brecha de género en el ámbito STEAM en la Unión Europea para 2050 podría aumentar el PIB en un 3%, según el Instituto Europeo de la Igualdad de Género
Entidad: FPEmpresaSalto de línea Dónde: toda EspañaSalto de línea Impulsa: Grupo EsprinetSalto de línea Enfoque: cumplir con los objetivos ODSSalto de línea Etapa educativa: Formación Profesional
Con la II Edición de los Premios Transferencia de Conocimiento de la FP, FPEmpresa quiere visibilizar el talento femenino en aquellas familias profesionales de FP donde la presencia de mujeres es testimonial. Para obtener el premio habrá que idear una solución tecnológica que contribuya a alcanzar al menos uno de los objetivos de desarrollo sostenible y fomentar la igualdad de género.
Entidad: Universidad Complutense de MadridSalto de línea Dónde: Madrid ( Escuela de Gobierno, Universidad Complutense de Madrid)Salto de línea Impulsa: Universidad Complutense de MadridSalto de línea Enfoque: Modalidad semipresencial, sesiones e-learning y sesiones presenciales en formato intensivo,Salto de línea Etapa educativa: Educación Superior
El Máster de Desarrollo Directivo para mujeres STEAM pretende formar a mujeres en habilidades directivas, visión estratégica y seguridad en la toma decisiones para trabajar en empresas y sectores de actividad STEAM.
Entidad: CASIOSalto de línea Dónde: Toda EspañaSalto de línea Impulsa: División Educativa CASIOSalto de línea Enfoque: Colección de recursos para ayuda en la educación en casa y en la escuela para que más chicas y chicos se interesen por la ciencia.Salto de línea Etapa educativa: Primaria, Secundaria y Bachillerato
Se trata de una serie de actividades didácticas enfocadas a dar a conocer el papel de las mujeres en las STEM/STEAM entre el alumnado.
Entidad: FujitsuSalto de línea Dónde: EspañaSalto de línea Impulsa: Gema Matín MonteroSalto de línea Enfoque:IImpulso y mas conocimiento de las carreras stem en edades tempranas a través de mujeresSalto de línea Etapa educativa: 4º de ESOSalto de línea Salto de línea El programa Fujitsu alumni tiene como Objetivo acercar el Sector de las Tecnologia de la Información a los jovenes en edades tempranas de su formaciónSalto de línea 1. Charlas presenciales en los colegios de las comunidades de Madrid, Barcelona, Sevilla, ValenciaSalto de línea 2. Videos inspiracionales de las mujeres profesionales en Fujitsu 3. Sesiones interactivas, mediante juegos y dinámicas participativas
Entidad: Fundación IberdrolaSalto de línea Dónde: MadridSalto de línea Impulsa: Fundación Empieza Por EducarSalto de línea Enfoque: Generación de referentes, sensibilización y descubrimiento práctico Salto de línea Etapa educativa: ESO y FPBSalto de línea Salto de línea STEM4 Girls son una serie de talleres científico-tecnológicos, con foco en el papel de la mujer, destinados a alumnas de Secundaria y Formación Profesional Básica en centros de alta complejidad. De esta manera, se enseñan conceptos de estas ramas de una forma práctica para generar un interés por las mismas.
Entidad: Empieza por educarSalto de línea Dónde:EspañaSalto de línea Impulsa: Empieza por educarSalto de línea Enfoque: Talleres impulsando el uso de la tecnologíaSalto de línea Etapa educativa: ESO y FPBSalto de línea Salto de línea Serie de talleres científico-tecnológicos, con foco en el papel de la mujer, destinados a alumnas de Secundaria y Formación Profesional Básica en centros de alta complejidad. De esta manera, se enseñan conceptos de estas ramas de una forma práctica para generar un interés por las mismas.
Entidad: JESUITAS EDUCSISalto de línea Dónde: ËcijaSalto de línea Impulsa: SAFA ÉCIJASalto de línea Enfoque: Fomento de las vocaciones STEMSalto de línea Etapa educativa: Infantil
El alumnado de infantil,, desarrolla un proyecto de investigación centrado en una científica donde conocen a su persona y el trabajo desarrollado, así como el contexto histórico y social, con el objetivo de visibilizar su labor e iniciar al alumnado en futuras científicas.
Proyecto financiado por la Fundación Española para la Ciencia y Tecnología (FECYT) y coordinado por la Universidad de Córdoba (UCO) profesionales de mujeres en el ámbito de la Ingeniería.
Entidad: Fundación ASTISalto de línea Dónde: Castilla y LeónSalto de línea Impulsa: Consejería de Educación de la Junta de Castilla y León, Fundación La Caixa, y Diputación de BurgosSalto de línea Enfoque: acercar el conocimiento tecnológico al ámbito rural de forma tempranaSalto de línea Etapa educativa: Primaria
Ruralbotic es un programa que acerca el pensamiento computacional y la tecnología a los centros rurales de Castilla y León, con el objetivo de dotar a estos alumnos de mejores oportunidades y dotarles de todas las herramientas para que puedan construir su futuro y el de las zonas en las que residen, combatiendo la despoblación.
Entidad: Fundación ASTISalto de línea Dónde: Castilla y LeónSalto de línea Impulsa: Consejería de Educación de la Junta de Castilla y León, Ayuntamiento de BurgosSalto de línea Enfoque: f3º y 4º de la ESO, Bachillerato, FP básica, FP medio, FP superior
Ruralbotic es un desafío de robótica educativa que invita a competir a alumnos de diferentes edades en dos categorías mediante la construcción de un robot y la superación de distintos desafíos. Los equipos finalistas se dan cita en la Gran Final, un evento nacional que pone a prueba las habilidades y conocimientos adquiridos.
Entidad: FPEmpresaSalto de línea Dónde: todo EspañaSalto de línea Impulsa: EsprinetSalto de línea Enfoque: cumplir con los objetivos ODSSalto de línea Etapa educativa: Formación ProfesionalSalto de línea Salto de línea FPEmpresa y Grupo Esprinet lanzan la III Edición de los Premios Transferencia de Conocimiento de la FP. La convocatoria tiene el principal objetivo de visibilizar el talento femenino en los ciclos de Formación Profesional donde la presencia de mujeres es testimonial. Para ello, ambas entidades lanzan el premio con el que se incentivarán las ideas que ayuden a la consecución de los Objetivos de Desarrollo Sostenible, en especial el ODS 5 sobre Igualdad. Además, con esa iniciativa se pretende fomentar la capacidad de innovación y de desarrollo de propuestas tecnológicas en el ámbito de la FP.
Entidad: Ayuntamiento de Esplugues de LlobregatSalto de línea Dónde: Esplugues de LlobregatSalto de línea Impulsa: Ayuntamiento de Esplugues de LlobregatSalto de línea Enfoque: incentivar la vocación científica y tecnológica a las niñas, chicas y jóvenes mediante talleres escolares y extraescolares y proporcionar referentes del ámbito STEAM a las niñas, niños y jóvenes espuguenses.Salto de línea Etapa educativa: Primaria, Secundaria, Bachillerato y Ciclos Formativos.Salto de línea Salto de línea +Dones³: Ciència, Talent i Tecnologia es un proyecto para reducir la brecha de género en los ámbitos STEAM en Esplugues de Llobregat, mediante la incentivación de la vocación científica y tecnológica de las niñas y chicas de la ciudad, la promoción del empoderamiento, la adquisición de competencias digitales desde una perspectiva de género para mujeres activas en el mercado laboral y proporcionando referentes de mujeres en el campo de la Ciencia y la Tecnología.
Entidad: Fundación de los Ferrocarriles Españoles (FFE).Salto de línea Dónde: Toda España.Salto de línea Impulsa: FECYT y FFESalto de línea Enfoque: Tecnología, ciencia, ferrocarril, talento joven, talento femenino, vocaciones.Salto de línea Etapa educativa: Todas.
Niñas al Tren de la Ciencia y la Tecnología pretende incrementar las vocaciones científicas y tecnológicas entre las chicas en el transporte ferroviario. Junto al impulso de las carreras STEAM, se pretende concienciar sobre la importancia del papel de la mujer en el mundo de la ciencia y la tecnología ferroviaria.